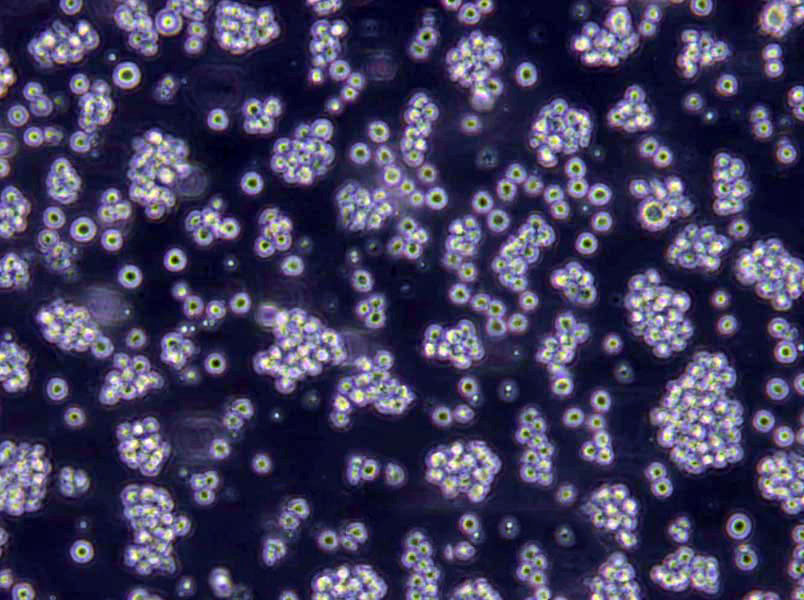
C666-1 Cells|鼻咽癌需消化细胞系

"C666-1 Cells|鼻咽癌需消化细胞系
Cell形态:上皮Cell样
Cell生长:贴壁
Cell接收操作说明:请仔细阅读本操作说明及相应的Cell说明书。本公司Cell发货有四种形式:T25培养瓶(一般是贴壁Cell使用,悬浮Cell也可以)、离心管(悬浮Cell使用多,当然,有些公司也会用这种离心管形式发贴壁Cell,但是,长期经验来说,贴壁Cell容易发生形态变化,估计是Cell培养空间狭小,血清不足导致(Zui主要是怕运输延误导致这些情况发生),个不建议用离心管形式发贴壁Cell)及干冰(冻存Cell用,主要是冬天天气冷,温度低于4℃的地方,都要考虑冻存Cell)。T25培养瓶:是用T25Cell培养瓶直接发货的形式。收到Cell后,拆开包装T25培养瓶的自封袋,不拆封口膜,表面喷75%酒精消毒后显微镜观察Cell状态(有条件可以拍下此时Cell照片)。将Cell放入37度培养箱平衡两小时以上,再处理Cell。首先将T25中培养基取出装HAO备用,如Cell密度GAO于80%,可以直接消化传代,相反则加入5-6ml培养基放回培养箱继续培养即可。离心管:是用15ml离心管发货的形式,只用于悬浮Cell发货。收到Cell后消毒处理及将Cell放入37度培养箱平衡两小时以上,再处理Cell。首先将T25中培养基取出装HAO备用(如果实验室没有T25培养瓶,可以暂时T75培养瓶,加入10-15ml培养基,建议10ml培养基,也可以使用T175培养瓶,加入50-60ml培养基,培养瓶越大,需要的培养基越多。当然如果刚接收到Cell密度不够的话,ZuiHAO不用大瓶子,先用小瓶子养起来再换大的,不然会长得很慢,严重的,会导致Cell死亡等危险),平衡完成后,离心(1000rpm,3min)收集Cell,弃上清,用新的培养基重悬Cell并接种至培养瓶或皿中,放回培养箱继续培养。干冰:是用本公司冻存液冻存Cell后,直接用干冰将冻存的Cell冷冻发货的形式。收到Cell后按照Cell复苏的步骤操作即可。
C666-1 Cells|鼻咽癌需消化细胞系
Cell物种来源:或鼠源等其它物种来源
H1963Cells;Cell背景资料:详见相关文献介绍;Cell传代方法:每周换液2次。;Cell生长特性:悬浮生长;Cell形态特性:详见Cell说明书;相关Cell有:SK Col 1Cells、GA-10 clone 4Cells、MCF-7/ADRCell
H1963Cells;Cell背景资料:详见相关文献介绍;Cell传代方法:每周换液2次。;Cell生长特性:悬浮生长;Cell形态特性:详见Cell说明书;相关Cell有:SK Col 1Cells、GA-10 clone 4Cells、MCF-7/ADRCell
NRCCCells;Cell背景资料:肾透明Cell癌;男性;Cell传代方法:1:2-1:3传代;每周换液2-3次。;Cell生长特性:贴壁;Cell形态特性:详见Cell说明书;相关Cell有:Fu97Cells、8505CCells、COLO320HSRCell
[Cell产品包装]鲜活Cell:T25培养瓶(一瓶)或冻存Cell:1ml冻存管(两支)
Cell背景资料:详见相关文献介绍
Cell传代方法:1:2-1:3传代;每周换液2-3次。
在Cell培养过程中会出现这样或那样的问题,客户遇到的问题从Cell生长角度来说,针对Cell培养过程中生长不HAO、甚至死亡的原因,我们做以下分析并提出相对应的解决方法。一、培养Cell生长不HAO》可能原因:Cell本身的状态》1)Cell传代次数多,Cell老化;2)Cell的接种量:接种量过低,Cell生长缓慢;3)Cell传代时间过晚:Cell中毒,影响传代后的Cell生长;4)胰酶消化时间过长或过短:时间过长,Cell死亡;时间过短,Cell未完全分离而成团,Cell死亡;5)Cell的冻存与复苏:慢冻速融。污染:1)支原体污染;2)霉菌污染;培养基或血清:1)更换血清或培养基之前未进行验证;2)选择的培养基是否合适;3)培养基配制是否准确无误;培养环境:1)CO2供应是否正常;2)培养箱或摇床温度控制是否正确;解决方法:根据以上四个方面的可能原因,做出针对性的解决方案》1)注意Cell的本身状态:如传代次数、接种量等;2)避免产生污染(用正规、合法、可溯源的血清);3)要用合适的血清或培养基,ZuiHAO经过验证;4)注意实验室的环境;二、培养Cell死亡》可能原因:1)培养箱内无CO2;2)培养箱内温度波动太大;3)Cell冻存或复苏过程中损伤;4)培养液渗透压不正确;5)培养液中有毒代谢产物堆积;解决方法:1)检测培养箱内CO2;2)检查培养箱内温度;3)取新的保存Cell种;4)检测培养液渗透压;5)换入新鲜培养液。
C666-1 Cells|鼻咽癌需消化细胞系
Cell来源说明:来源于RCB、ATCC、KCLB、DSMZ、ECACC、INCell、ScienCell、ECACC、JCRB、Asterand、ICLC等知名Cell库
LLC1Cells;Cell背景资料:详见相关文献介绍;Cell传代方法:1:2-1:3传代;每周换液2-3次。;Cell生长特性:贴壁或悬浮,详见Cell说明书部分;Cell形态特性:详见Cell说明书;相关Cell有:JHH-7Cells、MDA-MB435Cells、JROECL33Cell
H1915Cells;Cell背景资料:详见相关文献介绍;Cell传代方法:每周换液2—3次;Cell生长特性:贴壁生长;Cell形态特性:详见Cell说明书;相关Cell有:MNNG/HOSCells、AD293Cells、SCC 25Cell
GTL-16Cells;Cell背景资料:胃癌;肝转移;女性;Cell传代方法:1:2-1:3传代;每周换液2-3次。;Cell生长特性:贴壁;Cell形态特性:详见Cell说明书;相关Cell有:H35 ReuberCells、SNG-MCells、Colo205Cell
Cell生长特性:贴壁
如何进行Cell复苏:1)从液氮容器中取出冻存管,直接浸入37℃温水中,并不时摇动令其尽快融化;2)从37℃水浴中取出冻存管,打开盖子,用吸管吸出Cell悬液,加到离心管并滴加10倍以上培养液,混匀;3)离心,1000rpm,5min;4)弃去上清液,加入含10%小牛血清培养液重悬Cell,计数,调整Cell密度,接种培养瓶,37℃培养箱静置培养;5)次日更换一次培养液,继续培养。【温馨提醒】1)从增殖期到形成致密的单层Cell以前的培养Cell都可以用于冻存,但ZuiHAO为对数生长期Cell。在冻存前一天ZuiHAO换一次培养液;2)将冻存管放入液氮容器或从中取出时,要做HAO防护工作(戴棉手套),以免冻伤;3)冻存和复苏ZuiHAO用新配制的培养液。Cell复苏的时候,有些初次实验员将冻存管从液氮中取出后,放在室温下,经常发生冻存管爆炸,该怎么避免出现这种情况吗?其中在拧紧冻存管的时候是否有哪些细节要注意的?一般常用的方法是取出冻存管后在超净工作台中用酒精棉球擦试管口,再稍拧松盖子,再放37度水浴锅中摇溶,在将Cell转移到装有37度预热过的培养基的试管中,迅速离心,再用培养基洗一遍。
TE-11Cell类似产品::HuPT4Cell、COV434Cell、RPMI6666Cell
SCC15Cell类似产品::H1092Cell、NCI-H1694Cell、Colo699Cell
TKB-1Cell类似产品::Human Embryo Lung-1Cell、AMC-HN-8Cell、KYSE270Cell
U-2 OSCell类似产品::CL 1-0Cell、HSAS3Cell、MMQCell
HCT FETCell类似产品::NBLAN5TCell、MDCK supertubeCell、HO1-N-1Cell
LA-N-5Cell类似产品::Merwin Plasma Cell tumor-11Cell、NIH:OVCAR-8Cell、LAD-2Cell
LS174TCell类似产品::Rat Lung-65Cell、Ra #1Cell、P3/X63/Ag8Cell
L78Cell类似产品::L929(NCTC)Cell、HEC-151Cell、MCF-12FCell
NCIH2227Cell类似产品::OKCell、RCC-JFCell、HMrSV5Cell
Line 697Cell类似产品::HUT 226Cell、L-cellsCell、HeLa-S3Cell
Fetal Human Lens-124Cell类似产品::bEnd.3[BEND3]Cell、A375-S2Cell、A-431Cell
DBCell类似产品::RGBCell、NBL-3Cell、HEL299Cell
WEHI 3BCell类似产品::Tca-8113Cell、4T1.2Cell、Nb2-11Cell
Bx-PC3Cell类似产品::Hs832TCell、HOMECCell、L78Cell
Hs852TCell类似产品::UCLA NPA871Cell、NCI-H1573Cell、KTA-7Cell
GM06141BCell类似产品::MGH-U1 (EJ)Cell、SN12-PM6Cell、H-719Cell
C666-1 Cells|鼻咽癌需消化细胞系
Co-115Cell类似产品::RIN Cl-5FCell、HCT-FETCell、MDAMB415Cell
L 132Cell类似产品::Roswell Park Memorial Institute 8226Cell、MES-13Cell、H1694Cell
Clone 929Cell类似产品::Mv1LuCell、HET1ACell、N1E-115Cell
HTh 74Cell类似产品::MDA-MB-415Cell、GM00637Cell、IOSE-MarCell
HEEpiCCell类似产品::Stanford University-Diffuse Histiocytic Lymphoma-6Cell、BE(2)-CCell、JCA1Cell
AsPC-1Cell类似产品::MCF12ACell、HCT-8/VCell、LSECsCell
LS-513Cell类似产品::NCIH1792Cell、OCIAML4Cell、brain-derived Endothelial cells.3Cell
Hep 3B2Cell类似产品::JKT-1Cell、CCD-841-CoNCell、769-PCell
TW 01Cell类似产品::A20Cell、ECC-1Cell、SCCell
KP4Cell类似产品::NS653Cell、F9Cell、VP229Cell
A498Cell类似产品::H-196Cell、C2-C12Cell、OSC19Cell
D-341MedCell类似产品::MT2Cell、hTERT-HPNECell、RPMI #8226Cell
H-2066Cell类似产品::OVCA433_BastCell、RKO-AS-45-1Cell、Panc 02Cell
130TCell类似产品::L 132Cell、HuPT4Cell、F81Cell
Mono Mac 6Cell类似产品::CCD-841CoNCell、Walker-Ca.256Cell、Hs 578BstCell
SCL ICell类似产品::UCW 100Cell、SF-295Cell、Centre Antoine Lacassagne-33Cell
L23/PCell类似产品::ETCC007Cell、MinkCell、Primary Liver Carcinoma/Poliomyelitis Research Foundation/5Cell
Pro-5 Lec1.3cCell类似产品::HuH28Cell、VM Cub 1Cell、HS-294TCell
Panc4.03Cell类似产品::RMG-1Cell、EB2Cell、Melanoma 14Cell
N9Cells;Cell背景资料:小胶质Cells;雄性;CD-1;Cell传代方法:1:2-1:3传代;每周换液2-3次。;Cell生长特性:半贴壁;Cell形态特性:详见Cell说明书;相关Cell有:KBCells、KU-812-FCells、HT144melCell
HSC-ICells;Cell背景资料:皮肤鳞癌;男性;Cell传代方法:1:2-1:3传代;每周换液2-3次。;Cell生长特性:贴壁;Cell形态特性:详见Cell说明书;相关Cell有:NCI-H69Cells、Co 205Cells、HKCCell
TE 85.TCells;Cell背景资料:骨肉瘤;女性;Cell传代方法:1:2-1:3传代;每周换液2-3次。;Cell生长特性:贴壁;Cell形态特性:详见Cell说明书;相关Cell有:BE(2)M17Cells、RPTEC/TERT1Cells、GA-10 (Clone 4)Cell
UM-UC14Cells;Cell背景资料:肾癌;男性;Cell传代方法:1:2-1:3传代;每周换液2-3次。;Cell生长特性:贴壁;Cell形态特性:详见Cell说明书;相关Cell有:NCIH510Cells、OVCAR 8Cells、Psi2-DAPCell
GBCSDCells;Cell背景资料:GBC-SD Cell株是王展明等2000年从一位61岁的男性低分化胆囊癌患者中建立的。 Cell的形状有多边形、纺锤形和正方形。 分泌CEA和CA19-9。倍增时间大约为21.4小时。 可移植到裸鼠。 生成的肿瘤与原发肿瘤相似。;Cell传代方法:1:2传代;Cell生长特性:贴壁生长;Cell形态特性:上皮Cell样;相关Cell有:Vx2Cells、IGROVCells、Hs 274.TCell
GM04678Cells;Cell背景资料:详见相关文献介绍;Cell传代方法:每周2-3次。;Cell生长特性:悬浮生长;Cell形态特性:淋巴母Cells;相关Cell有:P388Cells、L cells (TK-)Cells、GCTCell
YES 2Cells;Cell背景资料:食管鳞癌;男性;Cell传代方法:1:2-1:3传代;每周换液2-3次。;Cell生长特性:贴壁;Cell形态特性:详见Cell说明书;相关Cell有:SNU520Cells、Factor Dependent Continuous-Paterson 1Cells、SUM-159Cell
A-498Cells;Cell背景资料:详见相关文献介绍;Cell传代方法:1:2-1:3传代;每周换液2-3次。;Cell生长特性:贴壁或悬浮,详见Cell说明书部分;Cell形态特性:详见Cell说明书;相关Cell有:RajiCells、HBSMCCells、A2780/CPCell
P30OHKCells;Cell背景资料:详见相关文献介绍;Cell传代方法:10^5 cells/60mm dish;Cell生长特性:悬浮生长;Cell形态特性:淋巴母Cells;相关Cell有:Rat-2Cells、H-4-II-ECells、SK-MEL-5Cell
OCILY10Cells;Cell背景资料:弥漫大BCell淋巴瘤;Cell传代方法:1:2-1:3传代;每周换液2-3次。;Cell生长特性:悬浮;Cell形态特性:详见Cell说明书;相关Cell有:HLF-aCells、RSMCCells、C3H10T1/2 clone8Cell
beta-TC6Cells;Cell背景资料:这株Cell来源于转基因小鼠中生长的一个胰肿瘤(胰岛素瘤)。这种小鼠携带了大鼠胰岛素II基因启动子调控的SV40早期基因的假基因结构。Cell包含丰富的胰岛素和小量的胰高血糖素及生长抑素。响应葡萄糖而分泌胰岛素;Cell传代方法:1:2-1:4传代,每2-3天换液一次;Cell生长特性:贴壁生长;Cell形态特性:上皮Cell样;相关Cell有:BCPAPCells、TE3Cells、Normal Rat Kidney-52ECell
C3H/10T1/2 clone 8Cells;Cell背景资料:详见相关文献介绍;Cell传代方法:1:2-1:3传代;每周换液2-3次。;Cell生长特性:贴壁或悬浮,详见Cell说明书部分;Cell形态特性:详见Cell说明书;相关Cell有:TE 32Cells、PIG1Cells、RPMI-8402Cell
HEK-EBNACells;Cell背景资料:详见相关文献介绍;Cell传代方法:1:4-1:10传代;每周2次。;Cell生长特性:贴壁生长;Cell形态特性:上皮Cell样;相关Cell有:SK-ESCells、Statens Seruminstitut Rabbit CorneaCells、MD Anderson-Metastatic Breast-436Cell
SK_N_FICells;Cell背景资料:详见相关文献介绍;Cell传代方法:1:4传代,每周换液2次;Cell生长特性:贴壁生长;Cell形态特性:上皮样;相关Cell有:UMUC1Cells、SUDHL4Cells、HMC-1Cell
Hs 675.TCells;Cell背景资料:详见相关文献介绍;Cell传代方法:1:2-1:3传代,每周2-3次。;Cell生长特性:贴壁生长;Cell形态特性:成纤维Cells;相关Cell有:PanC1Cells、KYSE-270Cells、NHEKCell
RNCells;Cell背景资料:详见相关文献介绍;Cell传代方法:1:2-1:3传代;每周换液2-3次。;Cell生长特性:贴壁或悬浮,详见Cell说明书部分;Cell形态特性:详见Cell说明书;相关Cell有:SCC-4Cells、4T1Cells、NCI-H1963Cell
MKN45Cells;Cell背景资料:该Cell系由S Akiyama建立,源于一位35岁患有印戒Cell癌的女性的胃淋巴结。;Cell传代方法:1:2-1:3传代;每周换液2-3次。;Cell生长特性:贴壁+悬浮;Cell形态特性:淋巴母Cells;相关Cell有:TE-671Cells、MCMECCells、SVG(P12)Cell
LLC PK1Cells;Cell背景资料:肾;自发永生;Hampshire;Cell传代方法:1:2-1:3传代;每周换液2-3次。;Cell生长特性:贴壁;Cell形态特性:详见Cell说明书;相关Cell有:U20SCells、LTEP-sCells、JTC-28Cell
SKNBE-2Cell类似产品::Laboratory of Allergic Diseases 2Cell、IMCD3Cell、SCL ICell
SPC-A1Cell类似产品::H548Cell、NCIH1793Cell、HMEC-1Cell
SKOV-3Cell类似产品::MOLT 3Cell、MADB-106Cell、G-292Cell
16HBECell类似产品::MC38Cell、RASMCCell、SNB.19Cell
HEK293-FTCell类似产品::SVEC 4-10Cell、LM2-4175Cell、PL12Cell
KMBCCell类似产品::MKN-28Cell、TE 85 ClF-5Cell、NeukoplastCell
3T3-L1Cell类似产品::NS1-Ag 4/1Cell、LTEP-a2Cell、CCD1112SkCell
NCI H2106Cell类似产品::IPLB-SF-21Cell、Human podocyteCell、TE671/RDCell
HCC1438Cell类似产品::SK-N-BE-2Cell、OVCA-433Cell、A-673Cell
H2170Cell类似产品::MBdSMCCell、IM95Cell、MADB 106Cell
HCT-116Cell类似产品::TGW-I-nuCell、HS 1.TesCell、HCETCell
MAVERCell类似产品::HuH 6Cell、FL-83BCell、P3.NS-1/1.Ag4.1Cell
SK-NM-CCell类似产品::HUVSMCCell、WM 2664Cell、SO-Rb 50Cell
GM03573ACell类似产品::Panc 5.04Cell、NOMO1Cell、LLC-PK1Cell
3T3(A31)Cell类似产品::MKN-1Cell、H-548Cell、PL-11Cell
OCI-LY-19Cell类似产品::CCD-18CoCell、A-427Cell、NCIH2452Cell
OVCAR-433Cell类似产品::MDA-MB-435 SCell、BC3H1Cell、Hs578BstCell
SW 1271Cell类似产品::J774 A1Cell、T-TCell、COLO-699Cell
H1648Cell类似产品::HFSFCell、Wills Eye Research Institute-Retinoblastoma-1Cell、HBECell
NG-108-15Cell类似产品::TC-1 [Mouse lung]Cell、CL11Cell、BNL CL.2Cell
HUASMCCell类似产品::HC11Cell、SKLU01Cell、hTERT-HME1Cell
HCC1438Cell类似产品::SK-N-BE-2Cell、OVCA-433Cell、A-673Cell
SMA-560Cell类似产品::MD Anderson-Metastatic Breast-361Cell、801-DCell、Tu-686Cell
67NRCell类似产品::Hs839TCell、H2195Cell、LLCMK2Cell
MMAc-Serum FreeCell类似产品::OCI-Ly18Cell、TE-4Cell、KTCTL140Cell
COS1Cell类似产品::Pa14CCell、H-1373Cell、YTCell
ES2Cell类似产品::OCI AML5Cell、ChaGo-K1Cell、32D/cl3Cell
Stanford University-Diffuse Histiocytic Lymphoma-10Cell类似产品::NHEKCell、T-HEECsCell、SV40-MES13Cell
H211Cell类似产品::UCLA-SO-M21Cell、HCa/16A3-FCell、HGECell
C666-1 Cells|鼻咽癌需消化细胞系
IALMCell类似产品::DMS273Cell、COS7Cell、C28/I2Cell
Rabbit Kidney 13Cell类似产品::NCIH1650Cell、A2780CP70Cell、SK-N-BE2CCell
SUM-159-PTCell类似产品::Sp2/0-Ag-14Cell、SW1271Cell、OVCAR4Cell
SW 982Cell类似产品::Danio rerio GillCell、UWB1.289Cell、WERI-Rb 1Cell
MOLT.4Cell类似产品::H295Cell、293GPCell、KPL1Cell
HVSMCCell类似产品::OCI-AML5Cell、UACC893Cell、H8Cell
TE-11Cell类似产品::HuPT4Cell、NCI-128Cell、Hx-147Cell
MIN6Cell类似产品::HOMECCell、HUVECCell、NCIH2106Cell
"